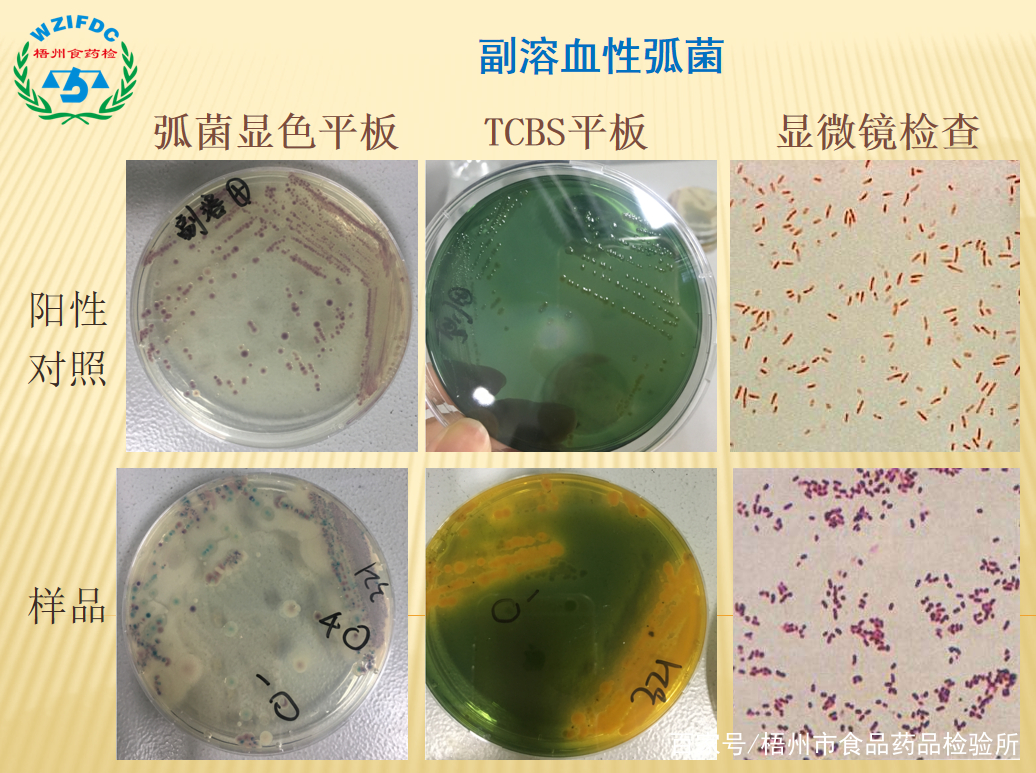
梧州市食品药品检验所在哪里,梧州市食品药品检验所电话

生测室团队介绍
生测室现有检测人员17人,其中研究生学历2人,本科学历12人,大专学历3人,含*党**员5人,是一个年轻化、知识化、专业化且充满活力的集体。科室按照“科学、公正、准确、高效”的质量方针,全体人员各司其职,密切配合,以积极向上、不断开拓、勇挑重担的精神,为梧州市食品药品安全保障工作添砖加瓦。科室在微生物、分子生物、动物实验及洁净环境检测领域上积累了较丰富的经验,能够为客户提供专业的检验检测服务,以严谨的工作态度为客户出具准确的检测结果。
检测范围
食品(保健食品)、药品、化妆品、环保、医疗器械(口罩)、洁净厂房
业务范围
(一)微生物试验
包括食品中卫生指标菌、致病菌的检验;药品微生物限度检查、无菌检查、微生物方法学验证、抗生素含量(效价)测定;保健品、化妆品中微生物检验;环保领域微生物的检验;以及开展相关科研项目。

微生物实验
(二)分子生物试验
主要有食品中致病菌的检测、病毒检测(诺如病毒、非洲猪瘟)、转基因食品的初筛、中药材鉴定(川贝母、蕲蛇、乌梢蛇等)、动物肉源性鉴定(猪、牛、羊肉等)、植物源性蛋白饮料中植物成份的鉴定;以及相关科研项目。

PCR产物分析
(三)动物试验
药品主要开展热原、异常毒性试验、溶血与凝聚、细菌内毒素检测和血药浓度监测;化妆品主要开展皮肤刺激性试验、急性眼刺激试验;食品主要开展急性中毒试验;以及相关科研项目。

小鼠实验
(四)空气洁净度检测
洁净区(室)环境等级评定、工程验收检测(包括食品、保健品、化妆品、GMP车间、医院手术室、动物实验室、生物安全实验室、无尘车间、无菌车间等)以及生物安全柜、洁净工作台检测。

生物安全柜高效过滤器检漏
(五)医疗器械检测
一次性使用医用口罩、医用外科口罩、医用防护口罩的细菌过滤效率、微生物指标或无菌检查、皮肤刺激性试验。可协助企业完成无菌口罩的环氧乙烷灭菌工艺验证。

口罩细菌过滤效率检测
仪器设备
生测室配备有众多先进仪器,包括普通PCR仪、荧光定量PCR仪和微滴式数字PCR仪三代PCR仪及相关配套仪器、VITEK-2全自动快速微生物鉴定智能分析系统、TEMPO全自动微生物定量系统、Leica DM2000显微镜、超低温冰箱(-80℃)、小鼠IVC屏障系统、WRY-2010微机热原测温仪、全套洁净环境检测设备以及口罩细菌过滤效率(BFE)检测仪等,可满足各类检验检测需求。

罗氏LightCycler® 96荧光定量PCR仪

VITEK-2 全自动快速微生物鉴定智能分析
近年业务成绩
1、参与了国家食品安全监督抽检、广西区食品监督抽检、广西区药品监督抽检任务,完成了各类食品、各品种药品的微生物检验任务。2017年至今完成各类检品的检验量累计约11000批次。
2、2018年6月生测室通过了梧州市卫健委关于二级生物安全实验室的备案审查工作。
3、2019年6月生测室获得了广西区农业农村厅授权的第一批能够开展非洲猪瘟检测工作的第三方实验室。
4、近年完成了医院、药企委托的药品微生物方法学适用性试验考察共15个。
5、2017年至今参加国家级能力验证获得满意结果17项,涉及微生物、转基因、非洲猪瘟等领域。
近年获得荣誉
1、2016年参加广西区总工会组织的“广西技能状元”大赛食品检验工的决赛,3名职工分别获得了全区“第二名”、“第七名”、“优秀奖”的好成绩;
2、2017年1名职工获得广西壮族自治区人力资源和社会保障厅授予的“广西技术能手”荣誉称号;
3、2018年3月获得梧州市“巾帼文明岗”;
4、2020年4月获得梧州市“工人先锋号”称号。


检验项目
食品微生物
菌落总数、大肠菌群、霉菌及酵母菌,以及常见致病菌(沙门氏菌、志贺氏菌、金黄色葡萄球菌、单核细胞增生李斯特氏菌、副溶血性弧菌、溶血性链球菌、铜绿假单胞菌等)
药品微生物
微生物限度检查及方法适用性、无菌检查及方法适用性、抗生素效价测定(微生物法)
化妆品微生物
菌落总数、霉菌和酵母菌、耐热大肠菌群、铜绿假单胞菌、金黄色葡萄球菌
环保微生物
水质、水和废水:细菌总数、粪大肠菌群
医院污水:沙门氏菌、志贺氏菌
公共场所:细菌、真菌
分子生物学试验
致病菌检验:食品中沙门氏菌、金黄色葡萄球菌、志贺氏菌、副溶血性弧菌、大肠埃希氏菌O157:H7、阪崎肠杆菌、单核细胞增生李斯特氏菌等
中药材鉴定:川贝母、蕲蛇、乌梢蛇等
病毒检测:食品和水中诺如病毒、非洲猪瘟病毒
转基因检测:大豆、水稻及其制品
动物肉源性鉴定:猪、牛、羊肉等
植物源性鉴定:植物蛋白饮料中花生、大豆、核桃、杏仁、芝麻、榛子等
动物实验
药品:热原、异常毒性、溶血与凝聚
化妆品:皮肤刺激性试验、急性眼刺激试验
食品:急性经口毒性试验
医疗器械(口罩)
细菌过滤效率、微生物限度、无菌、皮肤刺激性
洁净区(室)环境
尘埃粒子数、沉降菌、浮游菌、压差、换气次数、风速、照度、噪声、温度、相对湿度、紫外辐照度等
生物安全柜
尘埃粒子数、沉降菌、外观、高效过滤完整性、照度、紫外灯、下降气流流速、气流模式、温升
洁净工作台
尘埃粒子数、沉降菌、外观、扫描检漏、风速、空气洁净度、照度、气流状态
特色检验项目
1、微生物检验
包括食品(保健食品)、药品、化妆品、环保、医疗器械(口罩)等领域的微生物检验,科室配备有先进的VITEK-2全自动快速微生物鉴定智能分析系统,可协助食品、药品企业进行产品、洁净车间未知菌的鉴定。在药品微生物方法学方法开发方面具有较丰富的经验,近三年完成了医院、药企委托的药品微生物方法学适用性试验考察共15个。
2、动物实验
拥有120㎡的动物实验室,具备普通级家兔和屏障级小鼠的使用资质,为广西地市级食药检系统中唯一保留开展动物实验的实验室。主要开展药品中热原、异常毒性、溶血与凝聚的检验;化妆品中皮肤刺激性试验、急性眼刺激试验;食品中急性经口毒性试验;医疗器械(口罩)中皮肤刺激性试验。近年来,与玉林师范学院、梧州学院、梧州市中医医院等单位合作开展动物实验的科研工作,取得较好的成果。
3、洁净环境检测
拥有全套洁净环境检测设备,包括:激光尘埃粒子计数器、高效过滤器检漏仪、热球式智能风速计、数字式照度计、声级计、洁净环境检测仪、浮游菌采样器等。并具备开展洁净区(室)环境、生物安全柜、洁净工作台等全参数检测能力。2017年至今开展洁净环境检测697间/批。
4、血药浓度检测
与梧州市各大医院建立长效稳定的血药浓度监测科研平台,共同合作开展相关科研项目。2019年检测血药浓度样品超1000批次。
5、应急检验
2017年至今,生测室共参与了8起食品安全突发事件的应急检验,主要是食源性致病菌及诺如病毒等项目的快速筛查,检验样品接近200批次,及时有效的为食品安全事件的定性提供数据支撑。
在应急检验的样品中检出副溶血性弧菌
勇于担当,积极投入防疫物资检验工作
2020年1月底,新冠肺炎在全国蔓延,形势严峻。广西梧州制药(集团)股份有限公司为武汉疫区捐赠了安宫牛黄丸、清热镇咳糖浆、炎见宁片、紫雪散四个品种共6批次药品。为确保捐赠药品的质量符合标准要求,生测室实验员主动放弃年休假,积极参与到样品检验的一线工作中,加班加点,在最短时间内出具报告书,为疫情防控贡献一份力量。
2月起,梧州市许多企业相继转产口罩、防护服等防控物资,但由于缺乏相关生产经验,在改造、扩充口罩等防护用品的生产线上面临着许多难题。生测室技术人员积极配合市市场监督管理局,积极走访企业,围绕生产车间布局和改造、十万级洁净环境要求、产品质量标准和检测等多个方面提出专业性意见,认真做好企业帮扶及指导工作,并对企业委托的医疗器械洁净生产车间进行加急检测。


赴企业解决洁净车间改造问题
为尽快获得医用口罩的检验资质,在相关仪器设备采购回来之后,生测室充分利用自身在微生物检验方面的技术优势,紧急开展扩项工作,并在4月份获得一次性使用医用口罩、医用外科口罩、医用防护口罩的细菌过滤效率、微生物限度或无菌检查、皮肤刺激性试验的检验资质。在服务企业过程中,生测室勇担社会责任,急民之所急,解决企业检验难题,对企业委托送检的口罩、熔喷布样品做到即送即检。

进行口罩微生物检验

进行口罩环氧乙烷灭菌验证准备工作
截止6月10日,生测室累计检验疫情防护用品:口罩、熔喷布等样品80批次;派出60人次,奔赴梧州市周边的贺州、岑溪、平南、金秀等地开展洁净车间和实验室的检测工作,目前已完成20家企业约10000平方米的洁净室检测,发出报告243份。
展望未来,任重道远,砥砺前行,初心不改。在接下来的工作中,生测室将继续加强学习,对标先进、勇担责任、奋发有为,做新时代朝气蓬勃的检验工作者,为食品药品质量安全保驾护航,为检验检测工作的发展贡献自己的一份力量!